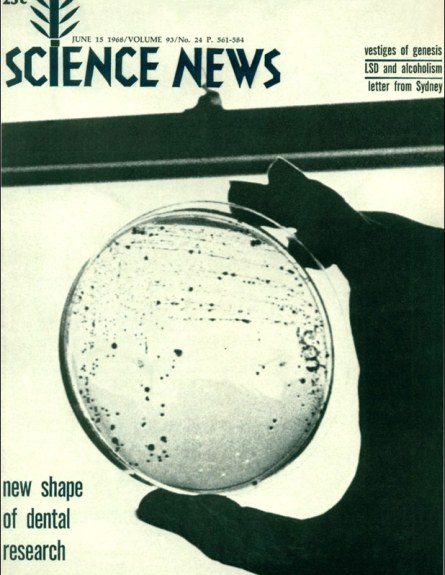

Science News Magazine: Current Issue
Vol. 93 No. #24
Archive Issues
Modal Example
« Previous
| Next »

Trustworthy journalism comes at a price.
Scientists and journalists share a core belief in questioning, observing and verifying to reach the truth. Science News reports on crucial research and discovery across science disciplines. We need your financial support to make it happen – every contribution makes a difference.